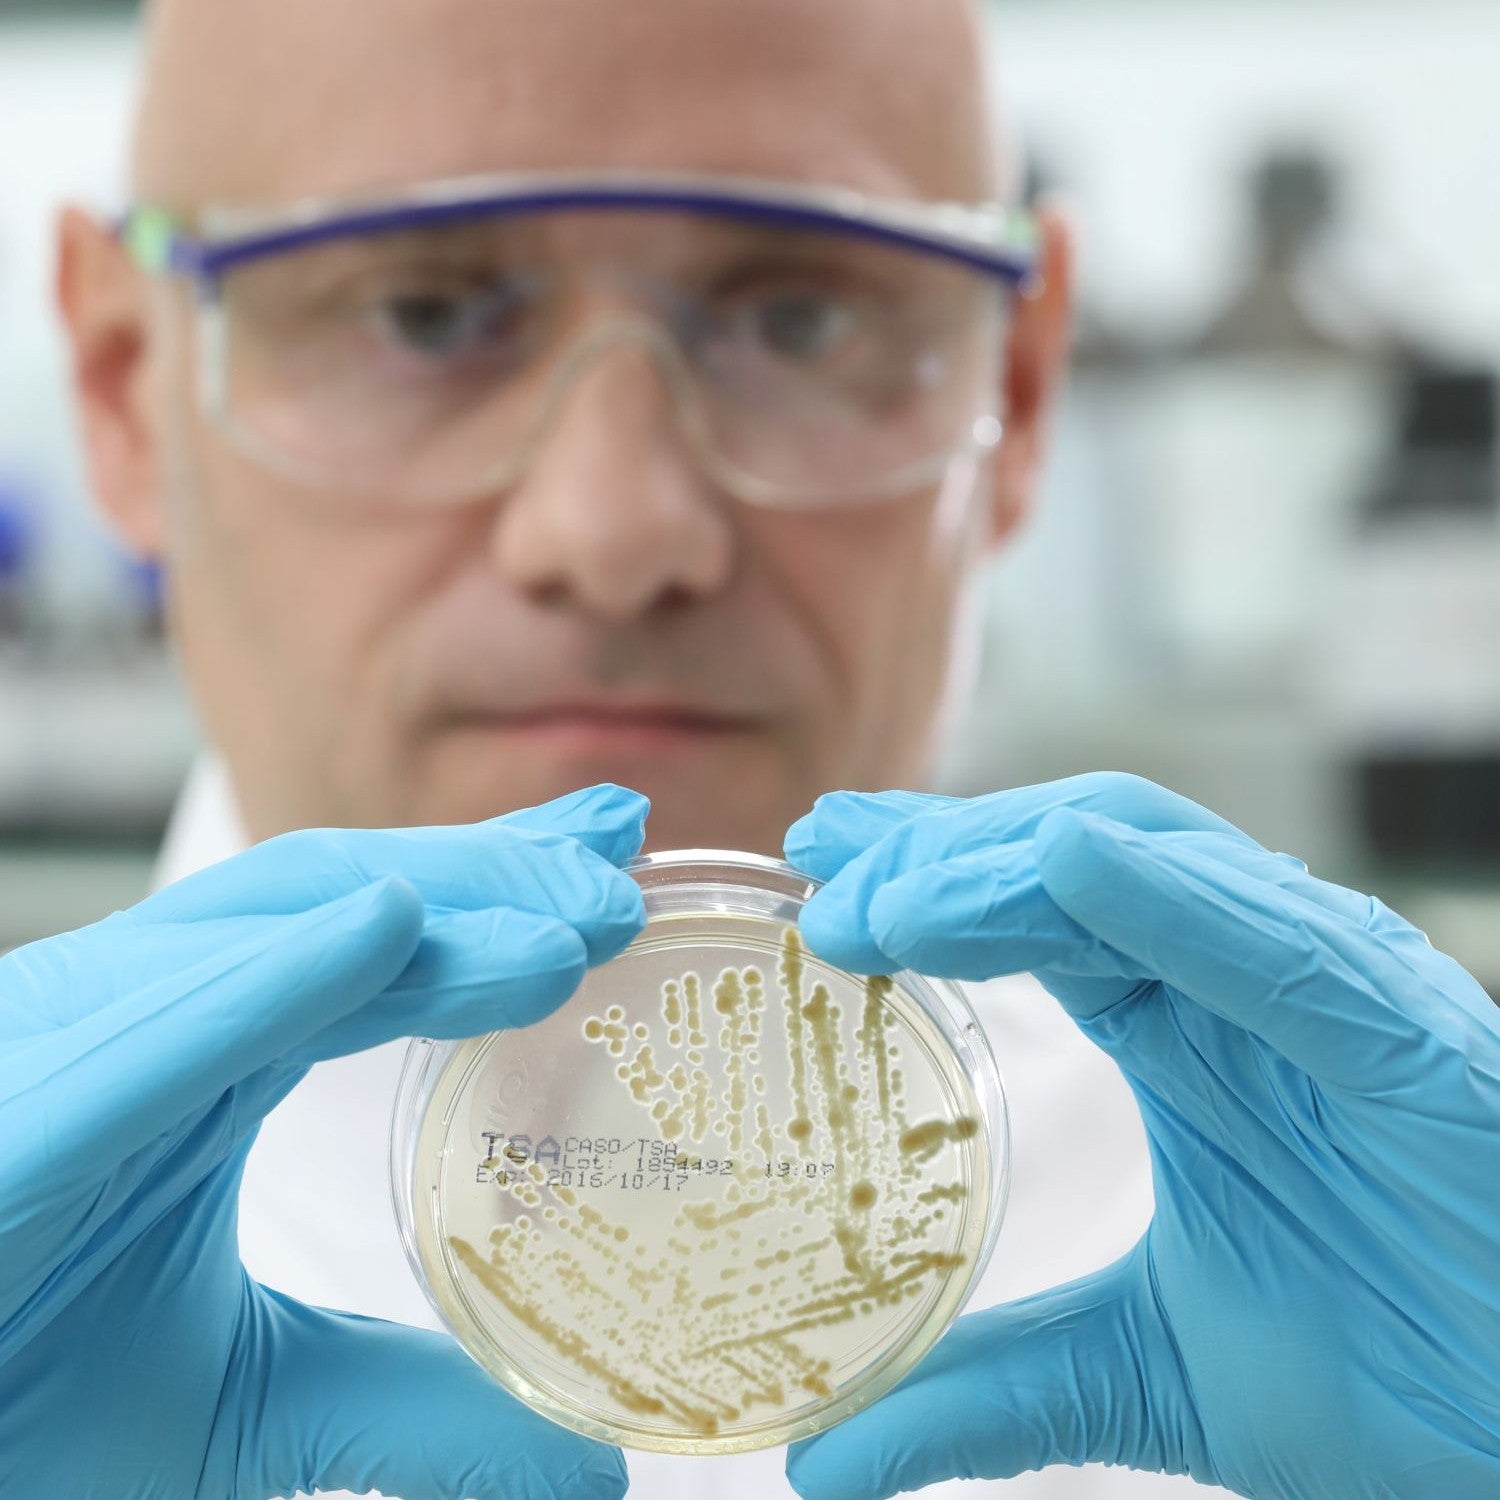
Mann mit Petrischale in den Händen

Die Produkte von Magnesium-Diasporal® entstehen mit höchstem Anspruch, unter besten Voraussetzungen und vor allem: gemeinsam.
Kreativ und entwicklungsstark: Das Ergebnis von Teamgeist
Um ein Arznei- oder Nahrungsergänzungsmittel zu entwickeln, das seinen Zweck bestmöglich erfüllt, müssen unterschiedliche Faktoren zusammenspielen. Es braucht fundiertes Wissen, moderne Labore und Produktionsanlagen sowie eine Umgebung, die die Zusammenarbeit fördert. In der gegenseitigen Inspiration können Menschen wachsen, Leidenschaft entwickeln und ihr Potenzial entfalten. Dafür schaffen wir bei Protina optimale Voraussetzungen.

Das „Wir“ ist unsere Schlagkraft
Wir arbeiten mit viel Engagement, Kompetenz und dem Anspruch, die Erwartungen unserer Kundinnen und Kunden zu erfüllen. Dabei liegt die Betonung immer auf diesem Wort: wir. Denn unser Teamgeist macht Protina erfolgreich. Mehr noch: nachhaltig erfolgreich. Davon sind wir bei Protina überzeugt. Wir verstehen uns als Einheit, die ihre Schlagkraft durch den Einsatz jedes Einzelnen unserer rund 200 Mitarbeiterinnen und Mitarbeiter gewinnt. Deswegen haben wir Vertrauen in- und Wertschätzung füreinander, tauschen uns offen und über alle Ebenen hinweg aus und setzen uns gemeinsam für das Erreichen unserer Ziele ein. Diese Firmenphilosophie leben wir – authentisch und konsequent.
Garantiert gute Qualität
Die Produkte von Magnesium-Diasporal® genügen höchsten Ansprüchen. Nicht umsonst ist Magnesium-Diasporal® eine der führenden Marken in deutschen Apotheken. Zudem werden die Produkte weltweit vertrieben – sie sind derzeit in 26 Ländern erhältlich. Jedes Präparat wird nach dem aktuellen Stand der Wissenschaft entwickelt. Dazu arbeiten wir nicht nur im Haus, sondern auch mit renommierten Forschern, Medizinerinnen und Ernährungsexperten aus aller Welt eng zusammen.
Investition in die Zukunft – bereichsübergreifend
Für das Entwickeln, Herstellen und Prüfen des Sortiments von Magnesium-Diasporal® können wir auf beste Bedingungen zurückgreifen. Bei Protina wurde und wird kontinuierlich in hochmoderne Produktions- und Logistikstätten, Verwaltungsgebäude, in Forschung und Entwicklung investiert. Das gilt ebenso für unser stetig wachsendes Wissensfundament. Deshalb fördern wir bei Protina die regelmäßige Weiterbildung unserer Mitarbeiterinnen und Mitarbeiter.
Und wir setzen auf die nächste Generation, indem wir sie dabei unterstützen, Erfahrungen zu sammeln, sich Wissen anzueignen und Kompetenzen zu schaffen. Mit Ausbildungen, Praktika für Pharmaziestudierende und das Begleiten von Abschlussarbeiten geben wir frischen Impulsen eine Chance.